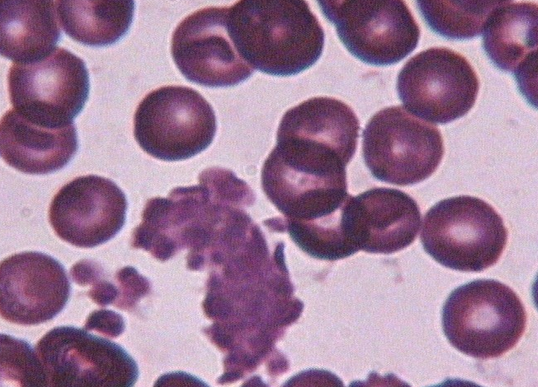

임상병리과
임상병리학과에서는 환자의 혈액, 소변, 체액(Cerebrospinal fluid, abdominal fluid, pleural fluid),조직 등의 가검물을 이용하여 질병의 진단과 치료 및 예후에 관계되는 검사를 시행하고 해석하는 것을 주요업무로 합니다. 임상병리학과에서는 다음과 같은 검사를 통해 환자의 상채롸 예후를 예측하고 있습니다.
각 검사 분야별로 우수한 임상병리학 전공 수의사가 검사결과 검증 및 판독, 임상자문 및 상담, 학술연구를 담당하고 있으며, 각종 검사 기법은 최신 수의학 지식 및 기술을 통해 정확한 병리학적 진단을 내려 임상 수의사에게 환자치료에 대한 방향을 결정하는데 도움을 주고 있습니다.
각 검사 분야별로 우수한 임상병리학 전공 수의사가 검사결과 검증 및 판독, 임상자문 및 상담, 학술연구를 담당하고 있으며, 각종 검사 기법은 최신 수의학 지식 및 기술을 통해 정확한 병리학적 진단을 내려 임상 수의사에게 환자치료에 대한 방향을 결정하는데 도움을 주고 있습니다.
-
 혈액 검사
혈액 검사
-
- 일반 혈액 검사(CBC) - PCV/HCT, MCHC, MCV, 빈혈의 종류 판단, Hemoglobin 함량
- 적혈구/백혈구의 형태적 이상, Platelet counts, Differential counts
-
 혈청 생화학 검사
혈청 생화학 검사
-
- 혈당 검사
- 간과 신장 기능 평가
- 전해질 불균형 검사
- Blood-gas 검사(산소 & 이산화탄소 포화도 검사)
- Calcium, Phophorus, Sodium, Potassium, Chloride, Magnesium 등
-
 세포학 검사
세포학 검사
-
- 세포 병리학적 검사 및 수술적 세포 병리학
- 검사 방법 : FNAB, Impressions, 체액
- Sample의 종류 : 혈액, 골수, 뇌척수액, 소변, 흉수와 복수를 포함한 체액
- 유핵세포 및 적혈구 확인
- 특별 염색을 통한 감염성, 무기물화의 요소확인
- 면역표현형 검사를 통한 종양/염증성 병변의 기원 확인
-
 요검사
요검사
-
- 세포학적 검사 및 crystal 확인
- Dipstick 검사법
-
 혈액응고계 검사
혈액응고계 검사
-
- ACT, APTT, PT를 이용한 혈액 응고계 관련 검사